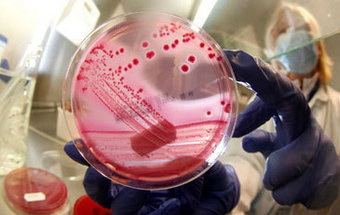
Identificada origem da epidemia: são os rebentos vegetais

E.Coli
Porque é importante resistir a provar a massa crua dos bolos de Natal
Agência nacional de saúde dos EUA alerta para os perigos de provar alimentos crus que devem ser cozinhados, como os que estão presentes nas massas dos bolos e bolachas
As alfaces sustentáveis do futuro
Mais do que plantar vegetais, a Grow to Green quer expandir uma nova tecnologia que põe a engenharia ao serviço da agricultura sustentável – e sem uma gota de pesticidas
Fazer surf aumenta exposição a bactérias resistentes a antibióticos
Um estudo recente concluiu que os surfistas estão expostos a um risco significativamente maior de terem bactérias resistentes a antibióticos nos intestinos. E a causa está na água do mar.
Quando a comida cai ao chão, a regra dos cinco segundos faz sentido?
Se deixarmos cair uma bolacha ao chão e a apanharmos rapidamente podemos comê-la? Um chão de mosaico é mais perigoso do que uma alcatifa? E há alimentos que se contaminam facilmente?
Deco alerta para o perigo de comprar carne já picada
A associação de defesa dos consumidores publicou um estudo realizado em 25 talhos de Lisboa e Porto que encontrou bactérias nocivas e aditivos alergénicos usados para fingir que a carne é fresca
Bill Gates financia investigação da vacina da malária em Portugal
Um grupo de investigação do Instituto Gulbenkian de Ciência, liderado pelo português Miguel Soares, vai ser financiado, durante dois anos, pela Fundação Bill e Melinda Gates. Desenvolver uma vacina contra a malária é o seu objetivo
Mão cheia de amendoins por dia pode ajudar a prevenir intoxicação alimentar
Os amendoins ajudam a melhorar a saúde intestinal e a capacidade do organismo para combater bactérias como a E.coli
Bactéria E.coli encontrada em folhas de alface
As autoridades sanitárias alemãs descobriram a bactéria E.coli em folhas de alface, num produtor hortícola de Fürth, na Baviera, quatro dias depois de ter sido levantado o alerta contra o consumo deste legume
Identificada origem da epidemia: são os rebentos vegetais
As autoridades sanitárias alemãs levantaram, por isso, a recomendação contra o consumo de pepino, tomate e salada, depois de se adensarem os indícios de que a origem do surto infecioso da bactéria E.coli são os rebentos de soja.
E.coli encontrada em beterrabas da Holanda
Uma nova variante da bactéria E.coli, diferente da que já matou 25 pessoas, foi detetada em rebentos de beterrabas holandesas exportadas para a Alemanha e Bélgica
Número de mortes na Alemanha sobe para 22
O número de pessoas que morreram na Alemanha devido ao surto de E.coli subiu para 22
Afinal, também não é da soja e origem da bactéria continua por apurar
Os primeiros testes conduzidos a rebentos vegetais de uma quinta orgânica no Norte da Alemanha, que se suspeitava estarem na origem de um surto da bactéria E.coli, tiveram resultados negativos
Bactéria pode estar nos rebentos de soja
As autoridades de saúde alemãs apontaram hoje os rebentos de soja cultivados no norte da Alemanha como a causa provável do surto da bactéria E.coli que já provocou até agora 22 mortes e centenas de infetados na Europa
Nova estirpe da E.coli é resistente a pelo menos a 8 tipos de antibióticos
A variante da bactéria e.coli, que já provocou a morte de 19 pessoas, é resistente, pelo menos, a oito tipos de antibióticos, segundo um comunicado publicado este sábado pelo Instituto Genético de Pequim
Análises aos dois casos suspeitos no continente deram resultado negativo
As análises aos dois casos suspeitos de infeção pela bactéria e.coli registados em Portugal continental deram resultados negativos, informou hoje a ministra da Saúde, adiantando que ainda se aguardam resultados relativamente ao caso referenciado na Madeira
FOTOS: No encalço da bactéria E.coli
Enquanto se multiplicam os casos de infeção com E.coli, os cientistas procuram, em laboratório, descobrir mais sobre esta nova - e letal - estirpe de uma bactéria tão comum. VEJAS AS FOTOS
10 perguntas e respostas sobre a E. Coli
Com a infeção por uma estirpe, até aqui desconhecida, da bactéria E.Coli, a fazer um número crescente de vítimas, confira este GUIA com perguntas e respostas
Três portugueses podem estar infetados
As autoridades de saúde portuguesas estão a acompanhar de perto os três cidadãos nacionais que chegaram de Hamburgo, na Alemanha, com sintomas de gastroentrite
Descoberto código genético da nova estirpe da bactéria E.coli
Cientistas alemães e chineses conseguiram decifrar o código genético de uma perigosa estirpe da bactéria E.Coli, descoberta permite tentar criar melhores terapias e formas de diagnóstico para debelar a epidemia
Primeiras análises realizadas pela ASAE a pepinos espanhóis deram negativo
A ASAE desencadeou, entre sexta e terça-feira, uma "operação de controlo" para verificar se havia à venda em Portugal pepinos provientes de Espanha
Associação de restaurantes e hotéis garante que Portugal tem melhor higiene e segurança do mundo
O secretário-geral da Associação da Hotelaria, Restauração e Similares (AHRESP) considerou que Portugal deve manter-se tranquilo apesar da quebra no consumo de produtos hortícolas porque o país tem o melhor sistema de higiene e segurança do mundo